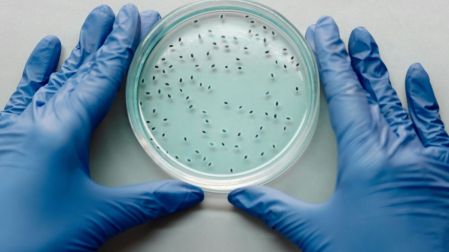
thumb

Científicos construyen virus para combatir las superbacterias
Científicos diseñan virus desde cero para combatir superbacterias resistentes, abriendo una alternativa a los antibióticos tradicionales.

La ciencia ha decidido contraatacar. En una era donde las bacterias se han hecho inmunes a casi todo, los investigadores están creando virus desde cero para destruirlas desde dentro.
Un estudio liderado por el Instituto Wyss de la Universidad de Harvard y publicado en Proceedings of the National Academy of Sciences propone una estrategia revolucionaria: construir bacteriófagos sintéticos capaces de eliminar bacterias multirresistentes, incluso aquellas que desafían los antibióticos más potentes.

¿Por qué crear virus desde cero?
La crisis de resistencia a los antimicrobianos ya no es una amenaza futura, sino una realidad mortal. Según la OMS, las superbacterias podrían causar más de 10 millones de muertes al año para 2050 si no se actúa con urgencia. Los antibióticos han perdido eficacia frente a organismos como Acinetobacter baumannii y Klebsiella pneumoniae, obligando a la ciencia a explorar caminos menos convencionales.
Ahí es donde entran los bacteriófagos: virus naturales que infectan exclusivamente bacterias. Pero los científicos no están usando estos virus tal cual existen en la naturaleza; los están rediseñando, modificando y construyendo desde cero para que sean más precisos, potentes y difíciles de evadir por las bacterias.
Un avance clave en esta línea fue logrado por un equipo de la Universidad de Exeter, que utilizó el método Golden Gate Assembly para sintetizar genomas completos de fagos con un control sin precedentes sobre sus propiedades.

¿Cómo funcionan estos virus personalizados?
A diferencia de los antibióticos, que atacan un amplio espectro de bacterias (incluyendo las benéficas), los virus sintéticos se diseñan para atacar solo a una especie específica. Esta precisión quirúrgica no solo los hace más eficaces, sino que también reduce el daño colateral en el microbioma humano.
Además, los virus creados en laboratorio pueden ser modificados genéticamente para superar las defensas bacterianas, replicarse con más eficiencia o incluso transportar cargas terapéuticas que refuercen el tratamiento. De esta manera, los bacteriófagos sintéticos funcionan como misiles teledirigidos en una guerra donde el enemigo se camufla y muta constantemente.
Según el estudio publicado en Frontiers in Cellular and Infection Microbiology, estos fagos de diseño han demostrado ser eficaces incluso contra cepas que han desarrollado múltiples mecanismos de resistencia, representando una esperanza tangible frente a infecciones letales en hospitales.

¿Qué tan cerca estamos de usar estos virus en hospitales?
La buena noticia es que los ensayos preclínicos ya muestran resultados prometedores. En estudios con modelos animales, los virus sintéticos lograron eliminar infecciones resistentes en un 90 % de los casos. El siguiente paso será validar su eficacia y seguridad en humanos, para lo cual ya se preparan ensayos clínicos con colaboración de instituciones como el MIT y el Broad Institute.
Además, un reciente informe señala que esta tecnología podría estar lista para aplicaciones terapéuticas en menos de cinco años, especialmente en casos donde los antibióticos han fracasado o no pueden usarse por alergias u otros factores.

¿Pueden las bacterias volverse resistentes a los fagos?
Sí, aunque no de la misma manera ni con la misma facilidad. Las bacterias pueden mutar para evitar que el fago se adhiera a su superficie, pero este proceso suele implicar un costo evolutivo para ellas. Y lo más importante: los virus también pueden evolucionar.
A diferencia de los antibióticos, que son sustancias químicas estáticas, los bacteriófagos son entidades vivas que pueden adaptarse junto con su huésped. En el laboratorio, los investigadores ya están utilizando algoritmos y simulaciones genéticas para anticipar cómo evolucionarán las bacterias y rediseñar los fagos en consecuencia. Una suerte de ajedrez molecular donde la ciencia lleva la ventaja.
Implicaciones éticas y riesgos de manipular virus
No todo es entusiasmo. Como toda tecnología emergente, la creación de virus plantea dilemas éticos. ¿Qué pasa si un virus sintético escapa del laboratorio? ¿Podría mutar y afectar a otros organismos? Aunque los científicos aseguran que los fagos modificados son específicos y no infecciosos para humanos, la preocupación persiste.
Instituciones de bioseguridad ya trabajan en marcos regulatorios para controlar la investigación y aplicación clínica de esta tecnología. Y aunque el potencial de los fagos sintéticos es enorme, su implementación deberá ser acompañada por una vigilancia rigurosa y una reflexión profunda sobre los límites de la manipulación biológica.
Una guerra invisible, pero programable
Estamos frente a una revolución en la medicina: diseñar virus a medida para combatir bacterias que se han vuelto invencibles. Lo que antes parecía ciencia ficción, hoy se construye en laboratorios de biología sintética con precisión milimétrica.
El enfoque ya no es solo curar, sino anticipar, rediseñar y evolucionar con el enemigo. Y mientras los antibióticos pierden su efectividad, los virus sintéticos ofrecen una luz poderosa al final del túnel. Sin embargo, como toda intervención profunda en los sistemas vivos, esta tecnología debe ser usada con prudencia, vigilancia ética y, ante todo, con sentido de responsabilidad.
EL EDITOR RECOMIENDA



